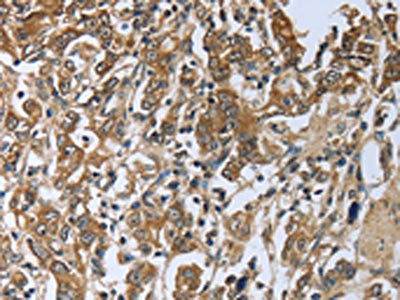

PRL Antibody
-
中文名稱:PRL兔多克隆抗體
-
貨號:CSB-PA568282
-
規格:¥1100
-
圖片:
-
其他:
產品詳情
-
Uniprot No.:
-
基因名:
-
別名:PRL antibody; Prolactin antibody; PRL antibody
-
宿主:Rabbit
-
反應種屬:Human
-
免疫原:Fusion protein of Human PRL
-
免疫原種屬:Homo sapiens (Human)
-
標記方式:Non-conjugated
-
抗體亞型:IgG
-
純化方式:Antigen affinity purification
-
濃度:It differs from different batches. Please contact us to confirm it.
-
保存緩沖液:-20°C, pH7.4 PBS, 0.05% NaN3, 40% Glycerol
-
產品提供形式:Liquid
-
應用范圍:ELISA,IHC
-
推薦稀釋比:
Application Recommended Dilution ELISA 1:1000-1:5000 IHC 1:50-1:200 -
Protocols:
-
儲存條件:Upon receipt, store at -20°C or -80°C. Avoid repeated freeze.
-
貨期:Basically, we can dispatch the products out in 1-3 working days after receiving your orders. Delivery time maybe differs from different purchasing way or location, please kindly consult your local distributors for specific delivery time.
-
用途:For Research Use Only. Not for use in diagnostic or therapeutic procedures.
相關產品
靶點詳情
-
功能:Prolactin acts primarily on the mammary gland by promoting lactation.
-
基因功能參考文獻:
- Circulating prolactin levels may not be higher in patients with Behcet's disease than in controls (meta-analysis). PMID: 29412808
- Cin85-deficient mother mice had reduced pituitary hormone prolactin secretion as a result of excessive dopamine signaling in the brain. Their offspring matured normally and produced their own pups; however, nurturing behaviors such as pup retrieval and nursing were strongly inhibited. PMID: 29158391
- PRL levels were lower in psychogenic non-epileptic seizure patients with a history of sexual abuse compared to healthy controls and healthy controls with a history of sexual abuse. PMID: 28927333
- In newborns, serum PRL and hGH levels show a positive correlation that can be explained by common regulatory factors or a drift phenomenon. A higher gestational week is associated with a higher PRL/hGH ratio. PMID: 28700563
- High normal circulating prolactin levels predict changes in haemodynamic indices and worsening endothelial function in healthy postmenopausal women. Particularly in young postmenopausal women, prolactin predicts accelerated arterial stiffening. PMID: 28332508
- In conclusion, the present study provides evidence supporting a significantly positive association between plasma prolactin levels and the risk of breast cancer. PMID: 27184120
- Our studies have demonstrated the essential role of endogenous PRL and CDK7 in the upregulation of PRLR by E2 and provide insights for therapeutic approaches that will mitigate the transcription/expression of PRLR and its participation in breast cancer progression fueled by E2 and PRL via their cognate receptors. PMID: 28423697
- GABA alpha2 and/or alpha3 receptor subtypes are involved in GABAergic modulation of prolactin secretion. PMID: 27128218
- This study revealed a significant association between the prolactin polymorphic variant rs1341239 and the development of hyperprolactinemia in patients with schizophrenia. PMID: 27776952
- High serum prolactin and vasoinhibin levels predict and may impact retinopathy of prematurity progression PMID: 27842054
- The production of PRL by Mvarphis was increased by unknown components of rheumatoid arthritis and rheumatoid arthritis synovial fluid, where it could contribute to disease progression. PMID: 28642278
- findings show that cysteine in the PRL catalytic site is endogenously phosphorylated as part of the catalytic cycle and that phosphocysteine levels change in response to Mg(2+) levels. PMID: 27856537
- Depression and anxiety in subfertile males are associated with higher secretion of PRL. PMID: 28456148
- Prolactin rs1341239 T allele decreases the risk of brick tea fluorosis in the Inner Mongolia in China population. PMID: 28152004
- In breast cancer, PRL hormone and its signaling pathway may play an important role in maintaining tumor differentiation state and in turn better patient outcome. PMID: 26980025
- Data indicate 12 single nucleotide polymorphism (SNPs) associated with increased prolactin levels in both plasma and cerebrospinal fluid (CSF). PMID: 27357110
- these data strongly support a critical interplay between prolactin and estrogen via PAK1 and suggest that ligand-independent activation of ERalpha through prolactin/PAK1 may impart resistance to anti-estrogen therapies. PMID: 26944939
- These data provide insight into the mechanisms guiding PRL-mediated breast cancer cell motility and invasion and highlight a significant role for phosphoTyr-PAK1 in breast cancer metastasis. PMID: 27542844
- changes in mRNA expression of selected toll-like receptors (TLR2, TLR4, TLR7), stress cytokine prolactin (PRL), and proand anti-inflammatory cytokines (TNF-alpha, IL-6, IL-12, IL-10) in peripheral blood monocytes of celiac disease patients, were investiagted. PMID: 28028951
- The review focuses on the role of prolactin in breast development, bone homeostasis and in breast cancer to bone metastases. (Review) PMID: 27782069
- Study demonstrate that PRL is necessary for the survival of (retinal pigment epithelium) RPE under normal and advancing age conditions and, identified SIRT2 and TRPM2 as molecular targets for the antioxidant and antiapoptotic actions of PRL in the RPE. PMID: 27322457
- This review addresses risk factors for rheumatoid arthritis (RA) linked to prolactin (PRL), the effects of PRL and vasoinhibins on joint tissues, blood vessels, and immune cells, and the clinical and experimental data associating PRL with RA. [review] PMID: 27026299
- Data suggest that the serum level of PRL was closely related to the antibody production and disease activity of systemic lupus eruthematosus patients. PRL concentration was dramatically reduced upon the remission of disease activity. PMID: 26678441
- prolactin levels and pituitary adenoma diameters may be associated with increased risk of cancer in patients with prolactinoma PMID: 26720589
- reduction in prolactin level is frequent after SRS and FSRT for prolactinomas; however, true biochemical remission is uncommon. PMID: 25410143
- the -1189 estrogen response element is the dominant response element involved in the human PRL transcriptional response. PMID: 26691151
- Data suggest that plasma kisspeptin and serum prolactin levels may be involved in the physiopathology of breast enlargement in newborns. PMID: 26831552
- Serum PRL was significantly higher in chronic hepatitis C patients compared to controls. PMID: 25912488
- PAK1 nuclear translocation is ligand-dependent: only PRL but not E2 stimulated PAK1 nuclear translocation PMID: 27003261
- Mean serum prolactin level was higher in the patients with recurrent miscarriage than in healthy women. PMID: 26370377
- findings revealed that the -1149TT genotype was correlated with higher levels of prolactin in serum and prolactin gene expression in peripheral blood mononuclear cells in women with systemic lupus erythematosus; study suggests that the -1149TT genotype may be a risk factor for lupus PMID: 26583155
- The results of our study suggest the association between vitamin D status and elevated macroprolactin levels in premenopausal women. PMID: 26179930
- Despite the fact that serum prolactin levels were found to be high during pregnancy, the contribution of macroprolactin was found to be insignificant. No relationship between thyroid autoimmunity and PRL, macroPRL or monoPRL % was found. PMID: 26091810
- PRL is ectopically activated in a subset of very aggressive lung tumors, associated with a rapid fatal outcome, in a cohort of 293 lung tumor patients and in an external independent series of patients; analysis of the PRL transcripts in lung tumors and cell lines revealed systematic truncations of their 5' regions, including the signal peptide-encoding portions. PMID: 24512221
- PRL-PRLR can escalate the impact of breast cancer on bone metastasis and the presence of PRLR in the tumor microenvironment of breast cancer bone metastasis has the potential to modulate the microenvironment to induce lytic osteoclast formation. PMID: 26586670
- Women with higher prolactin levels did not report significantly increased hostility. PMID: 25226401
- results suggest that up-regulation of IL-10 by prolactin might be modulating the pro-inflammatory response against mycobacterial antigens through the MAPK pathway PMID: 25218920
- there is a link between prolactin and mean platelet volume levels; in women with PCOS, elevated PRL levels may increase the risk of developing atherothrombotic events via the activation of platelets PMID: 25359296
- Our data extends prior research linking prolactin and invasive breast cancer to the outcome of in situ breast tumours and shows that higher circulating prolactin is associated with increased risk of in situ breast cancer. PMID: 25887963
- Cord blood prolactin level showed weak correlation with duration of full obstetric delivery, and duration of the second stage. PMID: 26160091
- the prolactin -1149 G/T polymorphism is associated with susceptibility to RA, but not SLE, in Caucasians [meta-analysis] PMID: 25724680
- Patients with diabetes mellitus and impaired renal function demonstrate a high urinary PRL excretion. PMID: 26299069
- serum levels were found to be higher in the infertile women than in controls PMID: 25345488
- The prevalence and predictors of hyperprolactinemia in 178 patients with liver cirrhosis of different etio-logies, were investigated. PMID: 24816831
- Studied the serum prolactin, cortisol, and ACTH stress response of intensive care unit (ICU) patients with severe sepsis/septic shock (SS) or systemic inflammatory response syndrome (SIRS) compared to healthy subjects. PMID: 25243181
- Report positive association between prolactin levels and the damage index (overall and its renal and cardiac/peripheral vascular domains), independently of other well-known risk factors in systemic lupus erythematosus. PMID: 24718588
- Hypertensive postmenopausal women with low risk for cardiovascular diseases have increased levels of prolactin, suggesting a possible role in the pathogenesis of hypertension PMID: 24861467
- a gene signature based on PRL-upregulated genes was associated with prolonged relapse-free and metastasis-free survival in breast cancer patients. PMID: 23758962
- REVIEW: Hypothalamic pituitary adrenal axis and prolactin abnormalities in suicidal behavior PMID: 24040800
- PRL constrains tumor-promoting liver inflammation. PMID: 25049387
顯示更多
收起更多
-
亞細胞定位:Secreted.
-
蛋白家族:Somatotropin/prolactin family
-
數據庫鏈接:
Most popular with customers
-
-
YWHAB Recombinant Monoclonal Antibody
Applications: ELISA, WB, IHC, IF, FC
Species Reactivity: Human, Mouse, Rat
-
Phospho-YAP1 (S127) Recombinant Monoclonal Antibody
Applications: ELISA, WB, IHC
Species Reactivity: Human
-
-
-
-
-